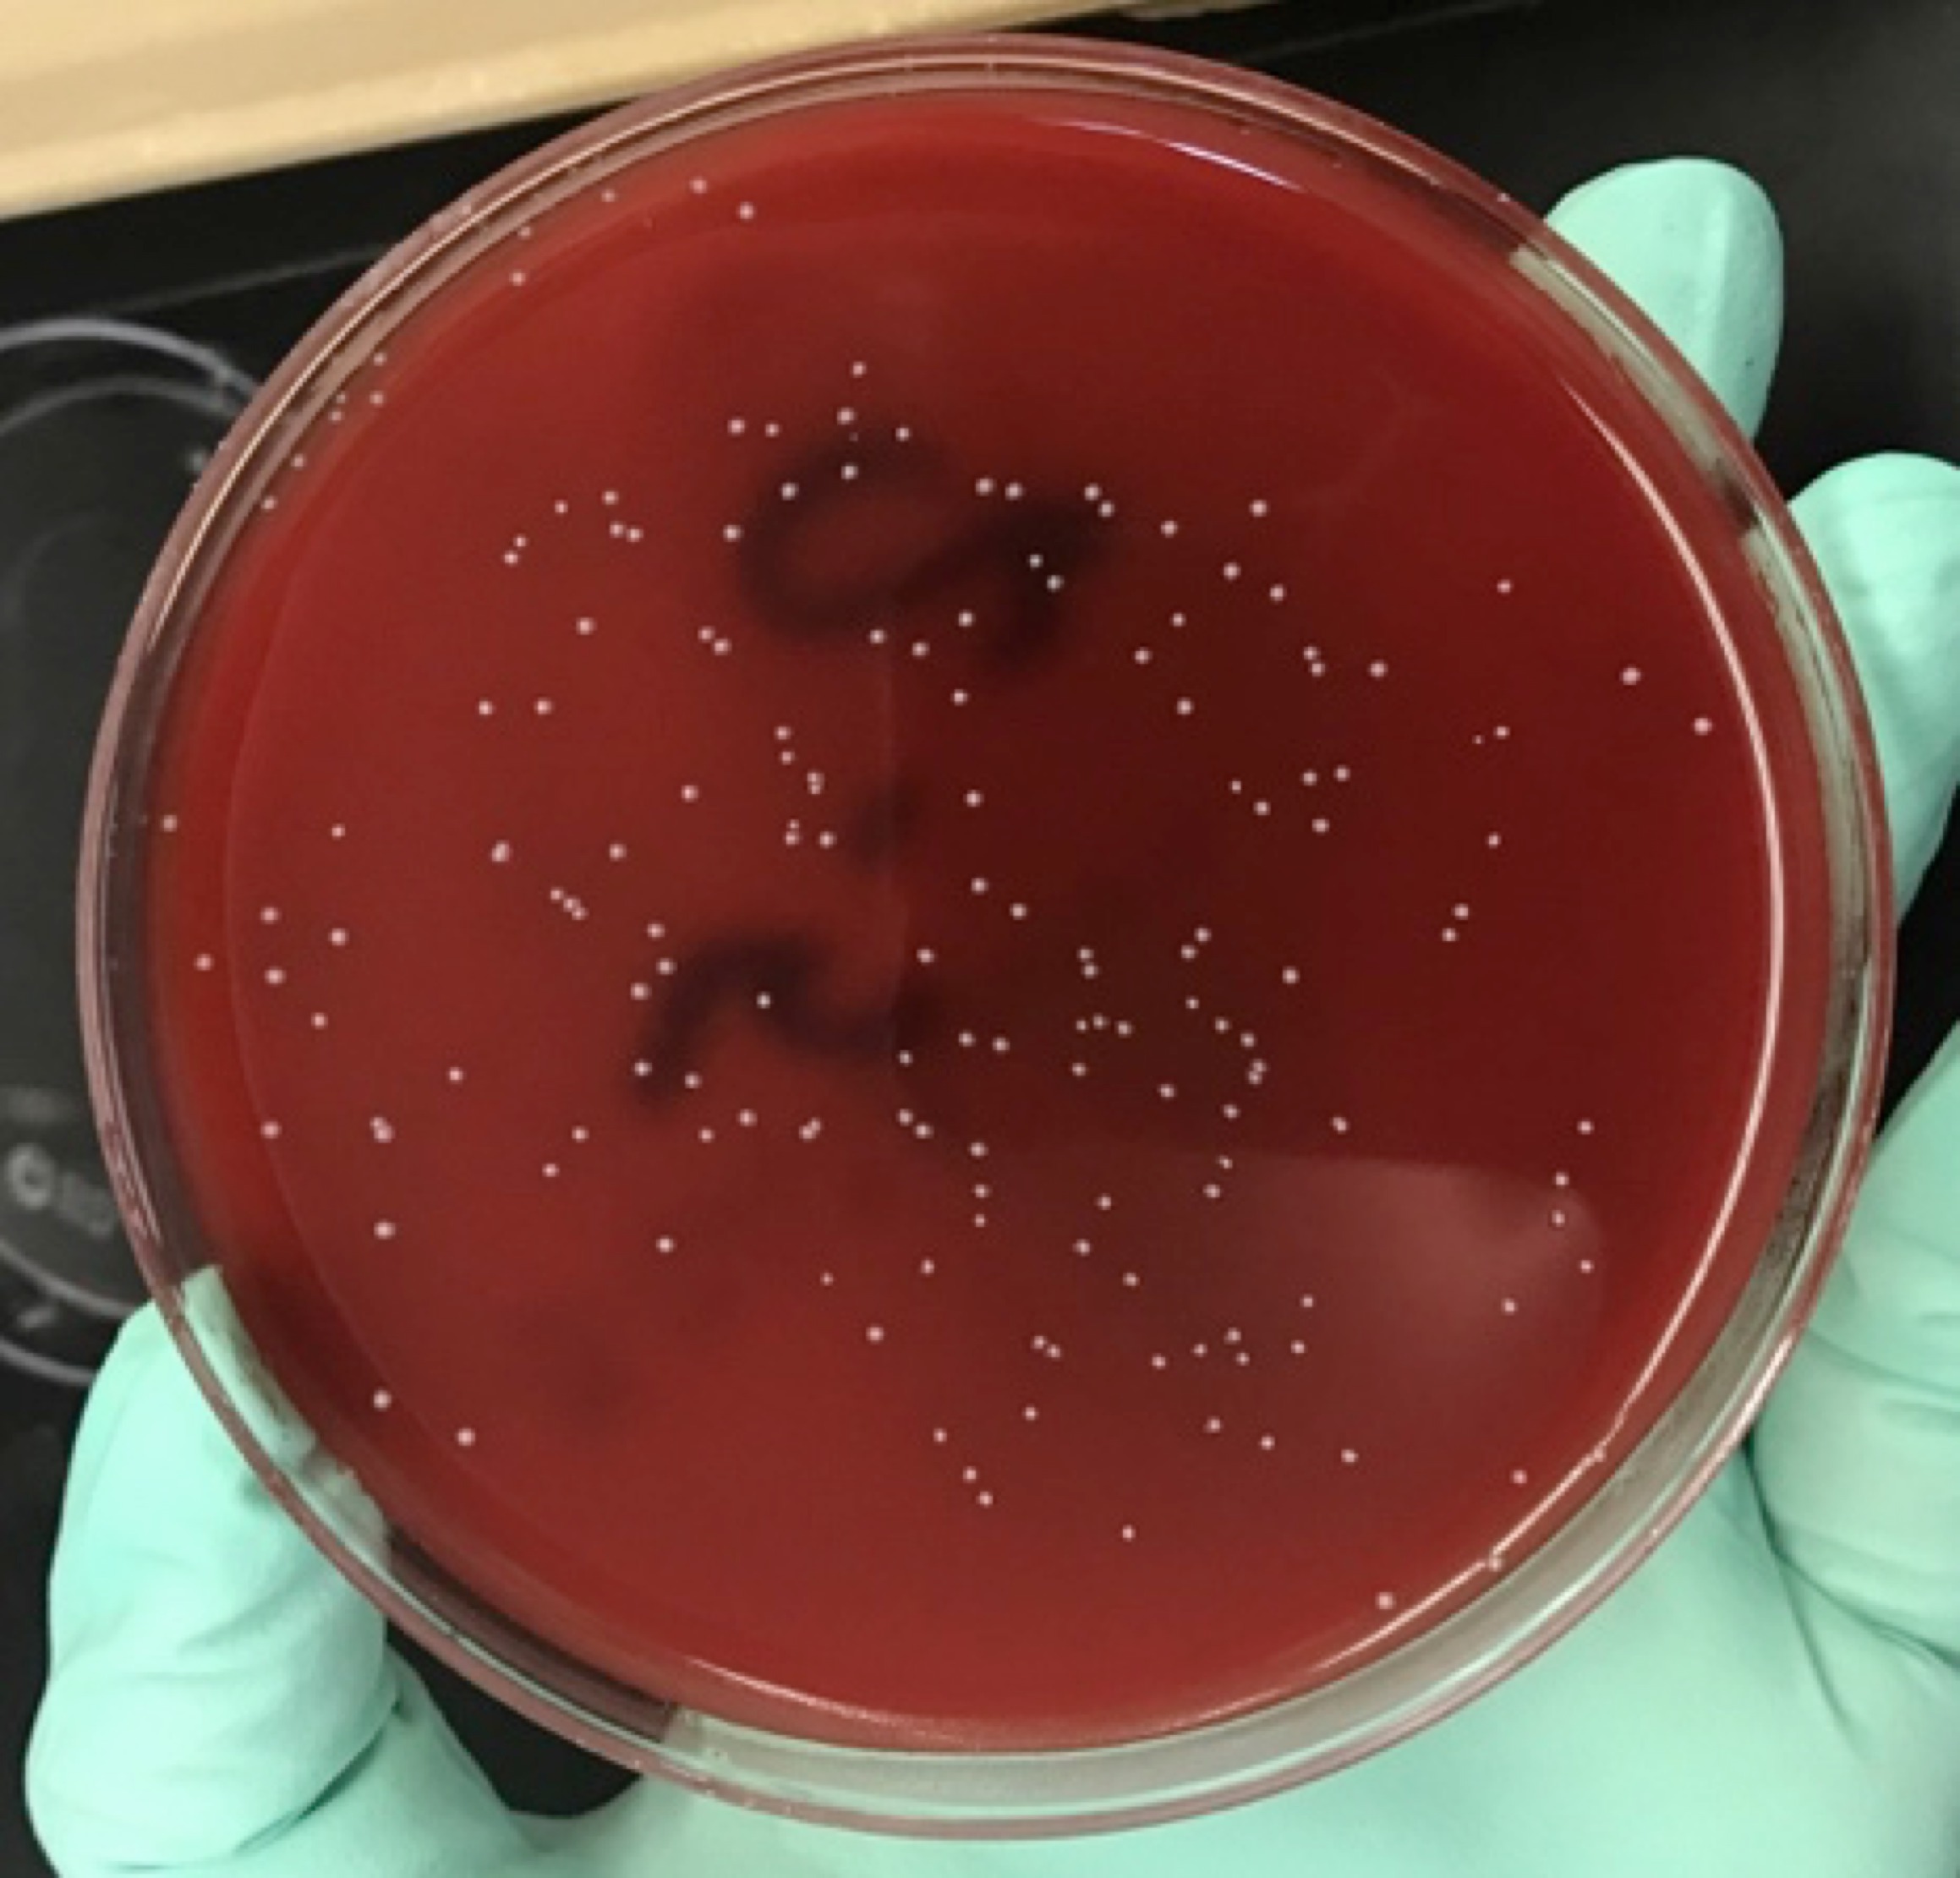
Colonies were counted for biofilm tests.

IADR Abstract Archives
Antimicrobial and Physical Properties of PVM/MA Copolymer Incorporated Acrylic Resin
Objectives: This study explored antimicrobial effects of adding PVM/MA copolymer into polymethyl methacrylate (PMMA) orthodontic/denture acrylic resin material and tested the effect of PVM/MA incorporation on the physical properties PMMA.
Methods: Samples were prepared with incorporation of different concentrations of PVM/MA into the PMMA (0%-control, 5%, 10%, 15%, 20%, and 25%). For antimicrobial and surface hardness tests, twelve disks (10x2mm) were used. Twelve samples (6.4x10x3.3mm) were prepared for flexural tests. For sample fabrications, specified weights of varying PMMA (Great Lakes Biocryl, USA) and PVM/MA were mixed. The samples were placed into a pressure pot at 30 psi for 30 mins and polished with 600-1200 grit sand-papers. For antimicrobial tests, the discs were transferred into sterile wells with 2.8 ml of fresh and homogenized saliva. After storage for 1h at 37°C, biofilms of S. mutans UA159 were formed on saliva-coated discs and placed in batch cultures at 37°C. Biofilms of S. mutans were formed in ultra-filtered tryptone-yeast extract broth and grown with samples for 44h. The biofilms were then analyzed for biomass (dry weight) and bacterial viability (colony forming units – CFU mg1 of biofilm). One-way ANOVA and Tukey’s test were used for statistical analysis.
Results: For the hardness, no significant differences were found between control, 5%, 10%, 15%, and 20% groups (p>0.05). However, statistic comparisons for flexural strength suggested that there was no significant difference between control, 5% and 10% groups only (p>0.05). Because of poor flexural strength properties, 15%, 20%, 25% groups were not studied for antibacterial comparisons. There were significant differences in bacterial adhesion (CFU mg 1 of biofilm with 1E5 dilution) between control (214.62), 5% (121.37) and 10% groups (46.37) (p<0.05).
Conclusions: Incorporation of PVM/MA copolymer into PMMA resins may be a promising solution to reduce bacterial adhesion and accumulation without changing physical properties of acrylic resin materials.
Methods: Samples were prepared with incorporation of different concentrations of PVM/MA into the PMMA (0%-control, 5%, 10%, 15%, 20%, and 25%). For antimicrobial and surface hardness tests, twelve disks (10x2mm) were used. Twelve samples (6.4x10x3.3mm) were prepared for flexural tests. For sample fabrications, specified weights of varying PMMA (Great Lakes Biocryl, USA) and PVM/MA were mixed. The samples were placed into a pressure pot at 30 psi for 30 mins and polished with 600-1200 grit sand-papers. For antimicrobial tests, the discs were transferred into sterile wells with 2.8 ml of fresh and homogenized saliva. After storage for 1h at 37°C, biofilms of S. mutans UA159 were formed on saliva-coated discs and placed in batch cultures at 37°C. Biofilms of S. mutans were formed in ultra-filtered tryptone-yeast extract broth and grown with samples for 44h. The biofilms were then analyzed for biomass (dry weight) and bacterial viability (colony forming units – CFU mg1 of biofilm). One-way ANOVA and Tukey’s test were used for statistical analysis.
Results: For the hardness, no significant differences were found between control, 5%, 10%, 15%, and 20% groups (p>0.05). However, statistic comparisons for flexural strength suggested that there was no significant difference between control, 5% and 10% groups only (p>0.05). Because of poor flexural strength properties, 15%, 20%, 25% groups were not studied for antibacterial comparisons. There were significant differences in bacterial adhesion (CFU mg 1 of biofilm with 1E5 dilution) between control (214.62), 5% (121.37) and 10% groups (46.37) (p<0.05).
Conclusions: Incorporation of PVM/MA copolymer into PMMA resins may be a promising solution to reduce bacterial adhesion and accumulation without changing physical properties of acrylic resin materials.